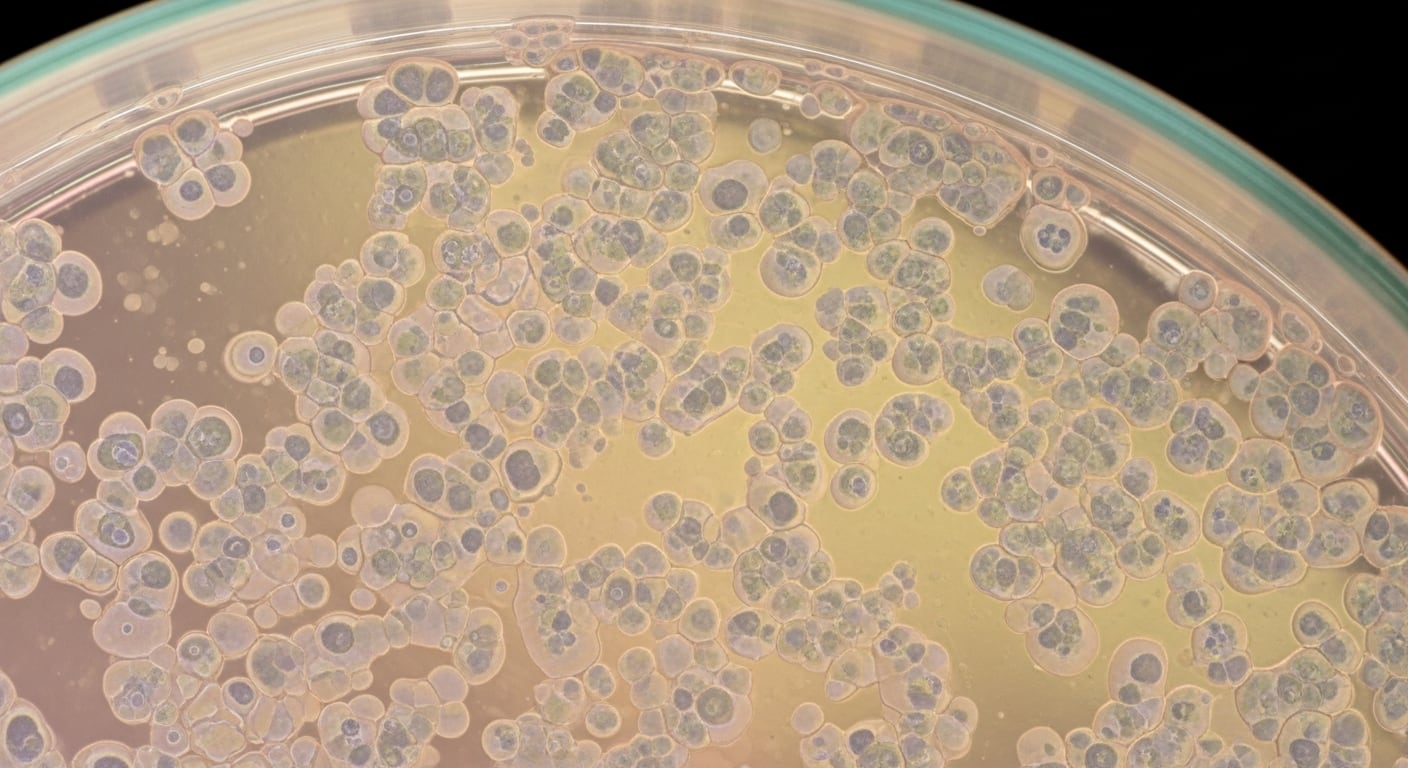
Los síntomas del síndrome imitan la intoxicación etílica, como niebla mental, problemas de coordinación, cansancio y cambios de humor (Imagen Ilustrativa Infobae)

Una rara condición médica ha desconcertado durante años a la comunidad científica: el síndrome de la autodestilación, también conocido como SAB. Esta extraña enfermedad provoca que el propio cuerpo de las personas produzca alcohol internamente, generando síntomas de intoxicación etílica sin haber ingerido una gota de licor.
Un nuevo y amplio estudio publicado en Nature Microbiology arroja luz sobre los mecanismos detrás de este fenómeno. El trabajo identifica bacterias intestinales específicas capaces de fermentar azúcares y liberar etanol en el intestino, lo que eleva los niveles de alcohol en sangre de manera suficiente para provocar daños físicos y sociales.
La investigación, que representa el mayor análisis realizado hasta la fecha sobre el SAB, explora cómo cambios en la microbiota pueden desencadenar episodios de intoxicación espontánea en pacientes que, muchas veces, enfrentan años de diagnósticos erróneos y estigmatización. El avance científico no solo ayuda a comprender mejor esta condición, sino que abre la puerta a nuevas posibilidades de tratamiento y diagnóstico, así como a una mayor visibilidad para quienes la padecen.
Cuáles son los principales síntomas
Conocido vulgarmente como el síndrome de autocervecería, se manifiesta a través de una gama de síntomas que imitan la intoxicación alcohólica convencional, aunque la persona no haya consumido dichas bebidas. Estos signos pueden variar en intensidad y frecuencia, dependiendo de la cantidad de etanol generada en el intestino y la capacidad del cuerpo para metabolizarlo.

En las primeras etapas, los pacientes suelen experimentar niebla mental, dificultades en la coordinación y un tiempo de reacción más lento. También son frecuentes el cansancio, problemas de memoria y la reducción de inhibiciones. Si los niveles de etanol en sangre siguen aumentando, las señales pueden agravarse y presentarse como agitación, problemas de equilibrio, visión borrosa y cambios de humor. Otros signos avanzados incluyen vómitos, habla arrastrada y enrojecimiento facial, detalla la Clínica Cleveland.
Fuera de los episodios de intoxicación, quienes padecen esta afección pueden sufrir molestias digestivas, como dolor abdominal, hinchazón, gases y cambios en la consistencia de las heces. También son comunes la fatiga, las sensibilidades alimentarias y una sensación persistente de resaca, agrega el centro médico estadounidense.
Las complicaciones asociadas a la autodestilación no se limitan al malestar físico. El exceso recurrente de alcohol en sangre puede provocar daño cerebral, lesiones por accidentes o caídas, depresión y, en los casos más graves, pensamientos suicidas. Además, el SAB conlleva riesgos de enfermedad hepática y, en niveles críticos de intoxicación, puede llegar a ser mortal, especialmente en niños o personas con menor tolerancia.
La naturaleza impredecible de los episodios puede interferir en la vida social, causar problemas legales y afectar el desempeño laboral o académico. Muchos pacientes enfrentan consecuencias sociales y médicas antes de obtener un diagnóstico correcto, lo que agrava el impacto de la enfermedad.
Qué dicen los expertos sobre la condición

La base radica en la actividad de los microbios intestinales capaces de fermentar los carbohidratos que llegan al intestino. Este proceso produce etanol, que puede pasar al torrente sanguíneo y elevar la concentración de alcohol en sangre hasta niveles de intoxicación. En condiciones normales, todos los humanos albergan bacterias y hongos en el intestino, entre ellos algunas especies productoras de etanol como la Saccharomyces cerevisiae. Habitualmente, el metabolismo corporal elimina las pequeñas cantidades de etanol generadas, impidiendo que alcancen el sistema circulatorio de forma significativa.
El problema surge cuando determinados factores, como el crecimiento excesivo de levaduras, un metabolismo comprometido o altos niveles de azúcar en sangre, alteran este equilibrio. En el SAB, la producción de etanol supera la capacidad de eliminación del cuerpo, lo que conduce a intoxicaciones espontáneas. Este desajuste puede estar motivado por una proliferación descontrolada de microbios fermentadores o por cambios en el entorno intestinal que favorecen su actividad.
Diversos elementos del sistema digestivo pueden contribuir al desarrollo del síndrome, ya sea por alteraciones en la microbiota, deficiencias metabólicas o condiciones que favorecen el crecimiento de estos organismos. Como resultado, el cuerpo se convierte en una “cervecería interna”, capaz de generar suficiente alcohol para provocar síntomas severos y complicaciones a largo plazo.
Hasta hace poco, se consideraba que las levaduras eran los principales agentes responsables del SAB. Sin embargo, los últimos estudios han identificado a ciertas bacterias intestinales como protagonistas clave en la producción de etanol en esta enfermedad.
El mayor análisis realizado hasta la fecha incluyó a 22 pacientes diagnosticados y a sus compañeros de hogar sanos. Los científicos observaron que las muestras de heces tomadas durante los brotes de la enfermedad producían mucho más etanol que las de los controles cuando se cultivaban en laboratorio.
Entre las bacterias detectadas con mayor frecuencia, destacan Klebsiella pneumoniae y Escherichia coli, ambas conocidas por su capacidad para fermentar azúcares y liberar alcohol. En particular, la presencia de E. coli aumentaba notablemente durante los episodios de intoxicación espontánea.
Otro hallazgo relevante fue el nivel elevado de enzimas microbianas implicadas en la fermentación durante los brotes, lo que sugiere que estos microorganismos aprovechan varias rutas metabólicas para producir etanol. Además, los investigadores comprobaron que el tratamiento con antibióticos podía reducir la producción de alcohol en las muestras fecales, lo que abre la puerta a nuevas estrategias terapéuticas.
Estos avances destacan la importancia del equilibrio microbiano intestinal y su influencia en la salud humana. La investigación también plantea interrogantes sobre la prevalencia real de la producción microbiana de etanol en la población general y su posible relación con otras enfermedades metabólicas o hepáticas.
Los tratamientos revelados por expertos

El abordaje presenta desafíos considerables, en parte debido a la rareza de la enfermedad y la falta de protocolos estandarizados. Sin embargo, las investigaciones recientes han permitido identificar nuevas rutas terapéuticas que podrían mejorar el manejo de los pacientes.
Tradicionalmente, el tratamiento ha incluido el uso de antifúngicos para controlar la proliferación de levaduras y la reducción del consumo de carbohidratos en la dieta, con el objetivo de limitar el sustrato disponible para la fermentación intestinal. No obstante, la implicación de bacterias ha llevado a explorar el uso de antibióticos dirigidos específicamente a estos microorganismos.
La investigación señala que el tratamiento antibiótico puede disminuir de forma notable la producción de etanol en el intestino durante los brotes, sugiriendo que una intervención selectiva sobre la microbiota bacteriana podría ser eficaz. Además, se ha observado que algunos pacientes presentan altos niveles de enzimas microbianas implicadas en la fermentación, por lo que terapias dirigidas a bloquear estas vías enzimáticas podrían ofrecer una alternativa prometedora.
Otra vía de intervención que ha mostrado resultados alentadores es el trasplante de microbiota fecal. En uno de los casos documentados en el ensayo científico, un paciente experimentó alivio de los síntomas y permaneció sin recaídas durante más de 16 meses tras recibir dos trasplantes de heces de un donante sano. Este procedimiento busca restablecer un equilibrio saludable en la flora intestinal y reducir la presencia de bacterias productoras de etanol.
